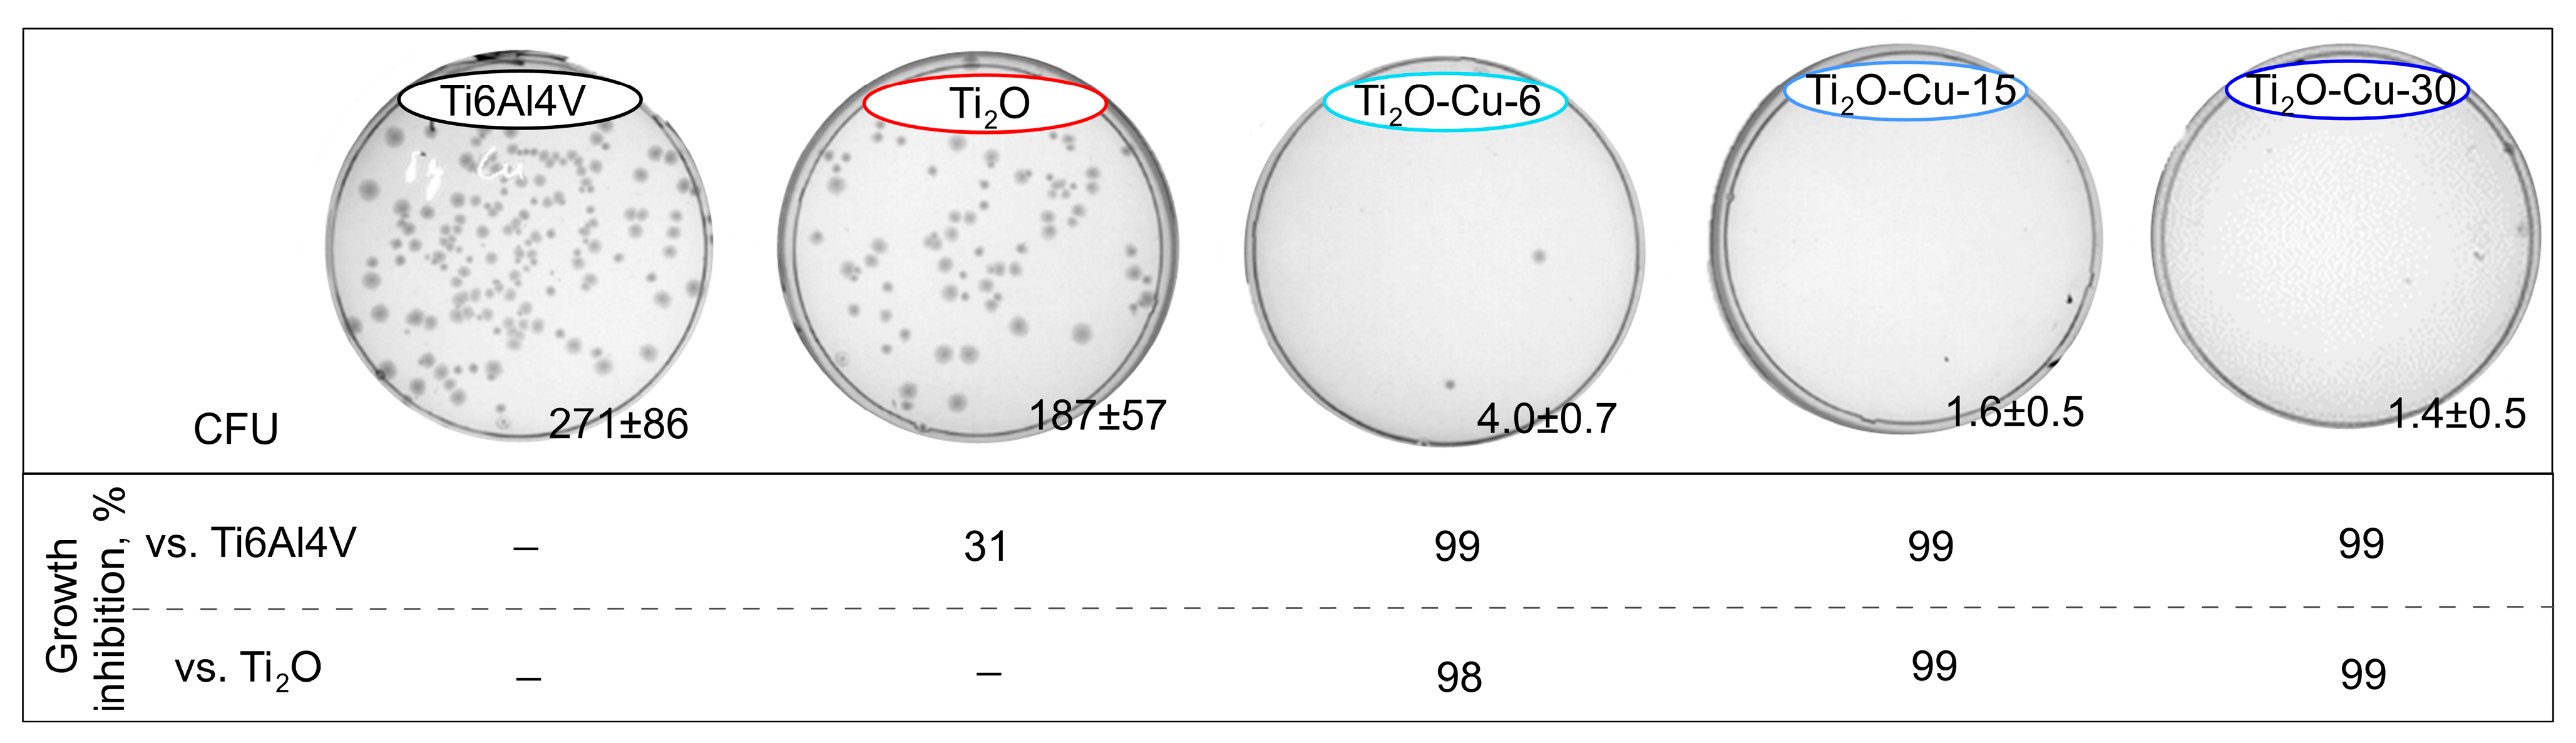
Coatings 15 01341 g009

1. Introduction
Despite their high strength, good toughness, low density, and elastic modulus similar to that of natural bone, titanium alloys still suffer from postoperative complications such as implant-related infections and poor bone integration [
1]. An implant’s performance life is influenced by the surrounding tissue integration and antibacterial properties at the hosting tissue-implant interface [
2]. The biological response of cells to an implanted material is determined largely by the chemical and physical properties of its surface, as well as topographical features at micro- and nanoscales. Hierarchical micro- and nano-modifications have been shown not only to stimulate osteogenic differentiation in osteoblasts [
3] but also to significantly enhance osseointegration in vivo [
4]. Based on their geometrical features, nanostructures can be classified as zero-, one-, two-, and three-dimensional [
5]. Considering both the complexity of fabrication and clinical feasibility, zero-dimensional nanostructures (e.g., nanoparticles, clusters, etc.) often seem to offer the optimal compromise between effective biological cues and manufacturability [
6]. Therefore, surface modifications of titanium alloys that include such nanostructures hold great promise for improving implant performance in a clinical setting.
Many studies have shown that surface titanium dioxide (TiO
2) layers, especially with different fractions of anatase and rutile phases, are more conducive to bone binding than bare titanium implants [
7,
8,
9]. TiO
2 has drawn a lot of interest in the biomedical industry due to its superior corrosion resistance and biocompatibility [
10]. Nonetheless, TiO
2 on its own lacks bactericidal activity under normal ambient conditions without exposure to ultraviolet or visible light [
11]. To overcome this limitation, the incorporation of essential trace elements with chemical stability and heat resilience, such as copper (Cu), has become a widely used strategy to impart broad-spectrum antibacterial properties. Moreover, Cu promotes the creation of new blood vessels, participates in enzyme-based processes for bone metabolism, and enhances the healing of early skin wounds [
12,
13]. At the same time, the release of copper ions allows them to pass through microbial membranes, a mechanism thought to be responsible for their bactericidal efficacy [
14]. When combined with other materials, CuO is thermodynamically more stable and less reactive than Cu
2O, which benefits the coating formulation, even though it has been claimed that Cu
2O nanoparticles have more antibacterial activity than CuO due to their lower oxidation state [
15]. However, excessive release of Cu ions can lead to cytotoxicity, which remains a major concern for the development of Cu-containing coatings. For instance, TiO
2 coatings doped with 3.0 g/L copper nanoparticles (NPs) exhibited clear cytotoxicity, while 0.3 g/L Cu encouraged osteoblast adhesion and proliferation [
7]. On the other hand, the coating synthesised with 3.0 g/L Cu was non-toxic to endothelial cells and promoted cell adhesion and proliferation. Therefore, to encourage implant ingrowth and preserve the antibacterial properties, a special sustained-release platform must be established that can maintain copper ions in proper amounts to minimise negative effects on surrounding tissue.
The surface of titanium implants can be altered using a variety of techniques, including loading with biocompatible coatings, such as titanium plasma spray [
16]; sandblasting with large grit and acid-etching (SLA) [
17]; anodic oxidation [
18], micro-arc oxidation (MAO) [
19]; and physical and chemical vapour deposition [
20]. Among these techniques, physical vapour deposition (PVD) processes enable the preparation of element-containing and zero-dimensional nanostructured coatings with precise control over composition, thickness, adherence, and microstructure [
21]. Furthermore, co-sputtering allows for precise control of component concentrations to build multicomponent composite layers [
22]. For instance, magnetron co-sputtered Ti-Cu coatings with varying element ratios (Ti81-Cu19, Ti49-Cu51, Ti29-Cu71, and Ti14-Cu86) were synthesised by Mahmoudi-Qashqay et al. [
23]. It was found that the binary amorphous Ti14-Cu86 layers with the highest percentage of Cu exhibited the best bactericidal rate against
S. aureus and
E. coli, and that the nanoscale surfaces became rougher and less wettable as the concentration of Cu increased. Liang and Li [
24] decorated TiO
2 nanorods with sputtered metallic copper coatings and post-annealed the as-synthesised layers at temperatures ranging from 200 to 400 °C. With the increase in temperature, the crystalline Cu
2O turned into co-existing Cu
2O-CuO phases, and at 400 °C, only TiO
2-CuO composite structure dominated. Both Refs. [
25,
26] used magnetron sputtering to construct TiO
2/Cu/TiO
2 multilayers with different thicknesses of Cu interlayer. Nevertheless, none of them exhibited copper or copper-containing oxide XRD peaks because the thick TiO
2 top layer screened the Cu metallic interlayer. By using alternating magnetron sputtering, Zhao et al. [
27] created NPs-Cu/TiO
2 composite coatings with varying sputtering times and Cu layer counts. They found that Cu nanoparticles scattered in an amorphous TiO
2 matrix grow in size and partially agglomerate with longer Cu deposition times. However, due to Cu’s oxidative nature and diffusion into TiO
2, Cu nanoparticle-embedded TiO
2 coatings have not received enough research attention [
28]. In contrast, Deibolt [
29] stated that Ag cannot reduce Ti
4+ due to the low heat of production of the most stable Ag oxide and the weak Ag–TiO
2 compound interactions. Furthermore, there are not many studies that focus on using copper on TiO
2 layers to provide antibacterial properties and a proper biological response of implants by PVD treatment.
For that reason, in the present work, we attempt to build upon these advances by constructing a superficially deposited copper-containing layer on TiO2 coating using a two-step glow-discharge sputtering process—first depositing TiO2 in a pure oxygen atmosphere, then coating its surface with Cu in an argon atmosphere. Following detailed characterisation of structure, composition, and copper ion release, we examine the antibacterial properties of the TiO2-Cu coatings against Escherichia coli, a pathogen relevant to many implant-associated infections. Simultaneously, we explore the biological activity of the coatings using MG-63 osteoblast cells. Through this approach, we aim to strike a balance between effective antibacterial performance and osteoblastic cell compatibility, potentially offering improved multifunctional surfaces for titanium implants.
3. Results and Discussions
Various studies have focused on achieving the best combination of surface features after modification by different approaches, considering their biocompatibility and antimicrobial activity. In this study, we have adopted a dual acid etching technique to obtain the initial surface roughness of the alloy and deposit TiO
2/Cu coating over it. After coating with TiO
2 (
Figure 1A,B), typical multi-crystalline coatings with uniform distribution on the micro-rough surface can be seen. Large numbers of rough oxide nanocrystals with irregular shapes appeared at higher magnification (
Figure 1C). Based on cross-sectioned sample micrographs, the average coating thickness was determined to be about 2 µm for the oxide and the underlying Ti layer (
Figure 1C).
The distribution of copper deposited on the TiO
2 layer was examined by optical microscopy and is shown in
Figure 2. The micrographs reveal that, unlike the thicker TiO
2 coating that uniformly covers the surface, ultrathin red-yellow copper deposits on high-aspect-ratio surfaces preferentially coat the asperity tops, while the valleys remain shadowed and uncovered. This behaviour results from geometric shadowing combined with limited adatom mobility and island growth at low thicknesses. Very thin coatings typically follow the island (Volmer–Weber) growth mode, in which nuclei form at favourable sites such as peaks and gradually coalesce as thickness increases [
31]. Because the substrate was not heated and copper deposition in argon was rapid [
32], adatoms had insufficient mobility to diffuse from peaks into valleys, favouring local nucleation at the initial landing sites [
33]. Furthermore, sharp peaks receive a higher local flux and act as energetically favourable nucleation centres.
Micrographs overlapped with EDS maps of copper in samples coated with varying concentrations of Cu are displayed in
Figure 3. The findings confirm the optical microscope observations that copper deposits tend to cover preferentially peaks (hilltops) rather than deeper valleys on the TiO
2-coated surface. It should be mentioned that, in contrast to bigger copper nanoparticles, smaller ones could not be distinguished or defined using the EDS resolution. However, with time increase, the formation of larger metallic copper clusters is seen. EDS was used to determine the coatings’ relative titanium and dopant copper concentrations, and the acquired results are depicted in
Table 1. Because of the high sputtering rate of Cu in Ar [
32], the surface concentration of Cu reached about 1.06, 1.37, and 2.3 at% after 6, 15 and 30 s deposition, respectively (
Table 1). This increase in Cu atomic concentration with deposition time is consistent with the expected accumulation of Cu atoms on the coated surface. Moreover, as the copper deposition time increased from 6 s to 30 s, the Ti/Cu atomic ratio decreased from 35.76 to 14.32, indicating progressively thicker Cu deposits on the TiO
2 surface. EDS was unable to provide an accurate measurement of the coatings’ oxygen content.
The grazing-incidence XRD (GIXRD) patterns presented in
Figure 4A show the phase composition and structural evolution of the coatings with increasing copper deposition time. Except for α- (JCPDS No. 01-1198) and β-Ti (JCPDS No. 09-0098) peaks from the pristine substrate, the coatings exhibited maxima for anatase (JCPDS No. 21-1272) and rutile (JCPDS No. 21-1276) TiO
2 phases. Typical diffraction maxima of rutile-phase crystal planes are visible in the XRD pattern. The patterns exhibited six diffraction peaks that correspond to the crystallographic planes (1 1 0), (1 0 1), (1 1 1), (2 2 1), (2 2 0), and (3 0 1), respectively. Four further reflections are associated with the anatase phase’s planes (1 0 1), (0 0 4), (2 0 0), and (2 1 1). According to some authors, the simultaneous presence of both phases in the coating is the most effective way to enhance the biological and physicochemical properties of the implant’s surfaces [
34]. Furthermore, small reflections around 2θ ≈ 43.3°, which can be assigned to the (1 1 1) copper plane, indicate the presence of metallic copper nanostructures on the TiO
2 surface. Since Cu has low loading on the fine TiO
2 dispersion surface, no extra reflections can be seen. In contrast to the pristine TiO
2 coating, a certain effect of an increase in the rutile reflection intensities from the surface after copper deposition was also observed. This phenomenon may be ascribed to the alteration of redox balance and the defective structure of TiO
2. Numerous metals, including Cr, Co, and Fe, that were deposited on the surface of TiO
2 reacted with the oxygen in TiO
2 to reduce TiO
2 and oxidise metals [
29]. Similarly, when Cu is deposited on TiO
2, the redox exchange can create oxygen vacancies (V
0) and Ti
3+ defect sites, modifying the TiO
2 lattice. Oxygen vacancies and Ti
3+ facilitate lattice rearrangement, which may lower the activation barrier for the anatase-to-rutile transformation and favour rutile transformation.
Since copper oxide phases were not observed in the grazing-incidence diffraction patterns of the coatings—likely due to their small thickness and/or peak overlap—a similar copper deposition on TiO
2 coatings was carried out for a longer sputtering time of 1500 s (
Figure 4B). In addition, (1 1 1), (2 0 0), and (2 2 0) Cu peaks (JCPDS No 04-0836) with a face-centred cubic crystal lattice, distant (1 1 0), (1 1 1), (2 0 0) and (2 2 0) diffraction peaks of Cu
2O phase (JCPDS No 77-0199) were formed. It follows that the deposited Cu layers were oxidised to Cu
2O, as indicated by the Bragg–Brentano XRD results. This oxidation likely occurred due to the interaction of the Cu layer with the underlying TiO
2 and/or in situ bulk oxidation of residual oxygen contamination in the sputtering chamber. Similar copper phases were reported by Potočnik et al. [
14] for superficially electrochemically deposited Cu on e-beam glancing angle deposited TiO
2, as well as Carvalho et al. [
28] for DC sputtered Cu on TiO
2 coatings. The gradual increase in the relative intensity and a decrease in the full width at half maximum (FWHM) of the Cu diffraction peaks suggest the formation of thicker and more continuous Cu layers, resulting from the coalescence and growth of Cu crystallites during prolonged sputtering. Moreover, the bulk phase composition of the coatings was found to be richer in anatase. It follows that the phase composition varies with depth in the coating due to Cu-induced surface reduction or lattice rearrangement.
Using AFM imaging, the surface topographic profiles are shown in
Figure 5. The coated groups exhibited a granular surface, suggesting homogeneous dispersion of the nanoparticles throughout the substrate surface. The tridimensional profile illustrates the peaks and valleys obtained for each surface. The average surface roughness (S
a) may be calculated from these pictures, and the findings are shown in
Table 2. Antibacterial applications may benefit from surfaces with nanoscale roughness, especially when paired with sufficient antibacterial compounds, such as copper. As indicated in
Table 2, the TiO
2-coated sample showed the highest values of S
a, followed by TiO
2/Cu-6. With longer Cu deposition times, S
a values decrease because copper preferentially accumulates on high asperities, rounding and levelling them. This reduces the height difference across the surface and therefore lowers the S
a roughness values, even if valleys are not yet fully coated. A higher Cu concentration results in a stronger tendency for Cu to aggregate, which reduces surface holes and gaps.
The results obtained for the skewness (Ssk), showing the asymmetry in the distribution of surface heights, demonstrate that after coating deposition, the value of this indicator is negative, indicating that the depressions of the profile predominate over the heights compared to the uncoated alloy. With longer Cu deposition time, Ssk becomes less negative. For Ssk > 0, the ridges are more than the valleys of the profile. Such Ssk values are obtained for both the etched alloy and TiO2/Cu-30 samples. This means that, in contrast with the other coated samples, the cell interactions of the etched alloy and TiO2/Cu-30 will be dominated by asperity tops.
Figure 6 shows the ends of the scratch tracks of all coated specimens before and after copper deposition. The scratch testing of the coatings deposited on the etched alloy revealed that all coatings have excellent adhesion to the substrate. No flaking was seen in the coatings up to a maximal load of 30 N.
The contact angle between the surface and SBF droplets was measured to define the coating’s wettability. The contact angle measurements indicate that all tested surfaces, even after 5 min of contact with SBF solution, remain hydrophobic (
Figure 7A). The least hydrophobic is the etched alloy, followed by the TiO
2–coated group. The hydrophobicity of the coatings increased with the amount of Cu present on their surface. However, this effect is likely due to the formation of a Cu
2O layer on the surface, rather than the presence of metallic Cu itself. The deposition of Cu onto the TiO
2 layer can enhance hydrophobicity through the surface oxidation of Cu to Cu
2O. A similar tendency was reported by Mahmoudi-Qashqay et al. [
23]. With a filled outer d-orbital, Cu has high electron saturation, which minimises dangling bonds and lowers surface energy [
35]. Elements with low surface energy enrich the surface, forming Cu–O bonds while showing a weaker affinity for hydrophilic groups such as –OH. Moreover, the increased rutile content near the surface after copper deposition can contribute to higher hydrophobicity since it was found that rutile-rich films become hydrophobic over time, while anatase-rich films remain hydrophilic, indicating rutile is more hydrophobic [
36]. As a result, TiO
2/Cu coatings exhibit greater hydrophobicity than the pure TiO
2 layer. However, as research shows that surface hydrophobicity and surface roughness are closely connected when the contact angle is larger than 90°, all wettability results can be ascribed to the high surface roughness values of the acid-etched substrate and coated samples.
Figure 7B shows the release profiles of Cu from the surface of the Cu-containing sample in SBF over 7 days of immersion. Cu ions can diffuse into the solution by dissolution or reaction with OH
– ions from the solution [
37]. The Cu release profiles of the three samples are similar. The highest absolute release was observed for the TiO
2/Cu-30 sample, followed by TiO
2-Cu-15 and TiO
2-Cu-6. For all samples, the highest Cu release was observed during the first 24 h. Such a burst way of release due to leaching of Cu species from the TiO
2 surface may cause cytotoxicity in the short term [
38]. Following that, the release proceeded gradually for a minimum of seven days. This release could ensure the implant surface’s ongoing antibacterial activity.
The long-term stability of implants in the organism depends on their interaction with body fluids. To determine the effect of the coatings on the corrosion resistance of Ti6Al4V surfaces in SBF, electrochemical impedance spectroscopy (EIS) tests were conducted. The results are presented in
Figure 8 and
Table 3. Compared with the uncoated Ti6Al4V substrate, the coated groups exhibited improved electrochemical behaviour. The Bode-impedance curve of the etched alloy (
Figure 8A) indicated a thinner and defect-rich oxide layer, whereas the coated specimens showed higher resistance values, reflecting the protective role of the TiO
2/Cu layers. As shown in the Bode-phase plots (
Figure 8B), the substrate alloy demonstrated a single capacitive response with a phase angle approaching −80° in the medium-low frequency range, confirming its ability to form a passive surface [
39]. In contrast, the coated samples exhibited two distinct time constants, corresponding to the response of the coating/SBF interface, which is characteristic of multilayer protective systems. Notably, at both high and low frequencies, all coated surfaces displayed greater phase angles than the uncoated substrate, confirming their enhanced capacitive and barrier properties. Although the maximum phase angle values of all coated groups were somewhat decreased, roughly to −67 ÷ −50 degrees, the coated surfaces function as stable capacitors, providing durable protection in the corrosive SBF environment.
A semi-circle capacitive behaviour and a high impedance value are seen for all coated specimens in the Nyquist plot (
Figure 8C). It is commonly recognised that a semicircle’s diameter indicates its corrosion performance, with a bigger diameter often indicating greater corrosion resistance.
Figure 8C shows that the greatest arc radius was noted for the TiO
2-Cu-15 and TiO
2-Cu-30, whereas the etched Ti6Al4V sample had a lower impedance.
Figure 8D shows the electrical equivalent circuit (EEC) model that was used to fit the impedance values. Due to the porous oxide layer, the electrolyte resistance (R
s) is in series with a parallel combination (R
1//Q
1) for the high- and intermediate-frequency range response that includes the oxide layer resistance (R
1) and a constant phase element (Q
1). For the low-frequency response measurements, which could be related to the corrosion process, R
2 is connected in series with a second R
3//Q
3 sub-circuit in parallel. The charge transfer resistance, or R
3, is inversely proportional to the corrosion rate, and the double-layer capacitance represented by Q
3. The Q is an ideal capacitor when n = 1 and an inductor when n = −1 [
40].
In contrast to the substrate alloy, the R1 values for all coatings are noticeably lower than the R2 and R3 values, suggesting that the outer rough layer has lower barrier properties. Owing to the high roughness and low SBF wettability, penetration of the solution into the inner coating layers is expected to be less during the initial hours of testing of the copper-containing coatings. It was discovered that the R2 and Q2 parameters for every coated specimen were of the same order of magnitude. This effect occurs because the SBF solution can suppress corrosion by promoting the precipitation of protective compounds within the pores. As the copper deposition time increases, the n2 values rise as well, indicating that the oxide layer is becoming more homogeneous. The charge transfer resistance (R3) also has similar values, except for TiO2-Cu-30, which indicates a higher value. The capacitance of the double layer (Q3) was in the range 2–5.5 × 10−5 with n values about 0.6 for all coatings. The only alloy with a lower Q3 and n value that matches those of a perfect capacitor (n = 1) is the substrate alloy. Although the outer rough layer exhibited lower resistance, the porous structure allowed precipitation within the pores, further enhancing protection. Increased Cu deposition time promoted oxide coating homogeneity, with TiO2-Cu-30 showing the highest resistance values. Overall, the addition of superficial copper did not compromise the protective effect of TiO2, confirming that sputtered TiO2/Cu coatings provide durable corrosion resistance in physiological conditions.
The bacteria
E. coli, which is frequently used to test materials’ antibacterial qualities and is a prevalent pathogen that causes diseases linked to healthcare [
41], was used to test the bactericidal activity of TiO
2-Cu coatings. The Cu-containing coatings demonstrated extremely effective antibacterial activity against this important coloniser of implants, compared to TiO
2-coated and Ti6Al4V alloy.
Figure 9 depicts representative images of
E. coli colonies on the agar plates after culturing on the surface of each sample for 24 h. It can be seen that a large number of colonies covered the solid agar plates of the etched Ti6Al4V alloy and TiO
2-coated samples, indicating that
E. coli can normally grow after 24 h of contact with these groups. The lower hydrophobicity could, in turn, promote the adhesion of cells, including bacteria. The rougher pristine TiO
2-coated surface shows slightly higher bactericidal activity compared to the uncoated alloy, confirming that the TiO
2 material only shows activity when exposed to UV or visible light.
In contrast, a few live bacteria appeared on the agar plates of TiO
2-Cu-6 and, in general, no bacteria were found on the agar plates of TiO
2-Cu-15 and TiO
2-Cu-30 after 24 h of incubation. The percentage of inhibition compared to the TiO
2-coated sample was equal to 99.1% for TiO
2-Cu-6 and 100% for TiO
2-Cu-15 and TiO
2-Cu-30 groups. It follows that all copper-containing surfaces generate excellent antibacterial effects. Such an inhibitory effect of copper species decorated on the surface of TiO
2 can be related to the release and contact-killing mechanism of copper ions [
42]. Cu
2+ ions disrupt bacterial membranes by increasing permeability and releasing lipopolysaccharides, proteins, and intracellular molecules [
43]. In addition, interactions with sulphur-containing proteins in cell walls can alter their structure and impair key metabolic processes [
44]. Cu ions might also impair respiratory chain activity and disturb gene replication of bacteria [
37]. Additionally, scientists [
45] discovered that interaction with Cu, not ion release, activates the coating’s antibacterial property. A strong difference in contact killing activity was demonstrated between CuO and Cu
2O, with a higher antimicrobial effect for Cu
2O [
46]. According to other research, when Cu (I) oxides came into direct contact with proteins, they absorbed and denatured them more than Cu (II) oxides [
47]. By switching between the redox states of Cu
+ and Cu
2+ ions, Cu may behave as an electron donor or acceptor, which could be the mechanism behind the antibacterial characteristics. After coming into direct contact with the bacteria, these ions are taken up by the outer membrane and react with it in accordance with the element’s electronegative tendencies. Moreover, the hydrophobic surfaces usually effectively inhibit bacterial adhesion, which is consistent with our experimental results. It is extremely encouraging that all TiO
2-Cu-6, TiO
2-Cu-15 and TiO
2-Cu-30 groups achieved an R value greater than 99%, which translates to an almost 99% reduction of the bacterial burden.
In vitro cell viability tests are important to evaluate the biological performance of the coatings. The cell viability of the cultured MG63 cells for 24 h with all groups is presented in
Figure 10. After day 1, all experimental groups reduced cell viability compared to the etched Ti6Al4V alloy, possibly due to unfavourable interactions or excess copper concentration in the culture medium. The cytotoxic effect of Cu-containing surfaces corresponds to the increase in copper content on the surface of the coatings. Since the highest amount of copper was released during the first 24 h, and after that, the release was lower and stable, a second experiment after 24 h of immersion in PBS was conducted. The outcomes demonstrated less damage to the cells’ viability from the Cu-containing surfaces. However, all Cu-containing surfaces were found to be cytotoxic to MG63 after day 1, meaning that the Cu release levels from the surface of the coatings are not within the safe concentration and form for MG63 osteoblastic cell growth. A linear decrease in the number of alive cells was also found with the increase in Cu content in Cu-containing groups. The MTT activity of MG63 cells decreased in the following order: Ti6Al4V > TiO
2 > TiO
2-Cu-6 > TiO
2-Cu-15 > TiO
2-Cu-30 coated alloy. When the culture time was increased to 5 days, the cells slightly proliferated, indicating that such Cu-containing coatings were non-conductive to cell growth and had obvious toxicity.
Similarly, Zhang et al. reported a great inhibitory effect of microporous anatase and rutile TiO
2 coating doped with an even lower concentration of copper (1.93 wt%) on fibroblasts [
42]. On the contrary, anodised Ti–Cu alloy with Cu content of 5 wt% showed a higher proliferation rate and lower apoptosis rate of MC3T3–E1 cells compared to pure Ti samples [
48]. The excessive Cu
2+ ions are thought to interact non-specifically with macromolecules, thus changing their conformation and increasing clinical oxidative stress, finally leading to the dysfunction of cellular processes and cell apoptosis [
42]. It is thus believed that the high content of Cu on the surface alone seriously affects the viability of osteoblast cells by inhibiting spreading and cell viability. Hallab et al. [
49] provided in vitro studies about copper ion concentrations that show toxicity or adverse effects to MG63 osteoblastic cells. The results reported in their study are plotted in
Figure 11. Taking into account the ISO 10993-5 standard, a reduction in cell viability higher than 30% compared to the control can be considered cytotoxic [
50]. This indicates that the Cu ion content released from all deposited coatings is within the cell-safe range for the MG63 cell line.
At the same time, according to the standard [
50], samples with 100% cell viability are non-cytotoxic (grade 0). Viability of 80%–100% indicates slight cytotoxicity (grade 1), 50%–80% mild (grade 2), 30%–50% moderate (grade 3), and below 30% severe cytotoxicity (grade 4). Therefore, without initial soaking, TiO
2-Cu-6 and TiO
2-Cu-15 belong to the moderate (grade 3) cytotoxicity group, while TiO
2-Cu-30 demonstrate severe cytotoxicity (grade 4). The examined copper–containing coatings cause obvious toxicity toward osteoblasts even after 24 h of pre-immersion in PBS, which decreases copper ion release. This implies that the cytotoxicity and antimicrobial properties of the examined Cu-containing coatings are dictated not only by excess ions but also by direct contact between cells and Cu species that are not removed during immersion. The preferential deposition of Cu on asperity peaks rather than in valleys means that, even after pre-immersion in PBS to reduce ion release, cells directly encounter Cu-rich sites at the surface. With increasing deposition time, larger copper clusters form, leading to more pronounced direct contact between osteoblasts and metallic oxide Cu species. This correlates with the observed evolution of surface skewness (S
sk). The contact with the superficially located copper species may disrupt cell membranes, alter adhesion, or trigger oxidative stress locally at the interface. Therefore, the observed cytotoxicity cannot be attributed solely to excess Cu ion release but is strongly influenced by the topographical distribution and aggregation of Cu species. These results emphasise that both ion release kinetics and surface geometry, particularly the presence of Cu clusters on protruding features, govern the biological response of TiO
2/Cu coatings.
The nano-specific properties of superficially located copper impart greater toxicity and burst release of Cu ions over a short time frame in the biological media. Achieving an optimal implant design requires controlling both Cu release kinetics and surface exposure of Cu nanoparticles to minimise osteoblast toxicity while maintaining antibacterial properties. Therefore, the use of continuous layers could more effectively control Cu release, considering the decrease in the total area of interaction with the biological medium and cells. Moreover, since the metallic bond is weaker than the ionic bond, fewer copper ions will be released if Cu participates in the coatings in its stable oxide form.